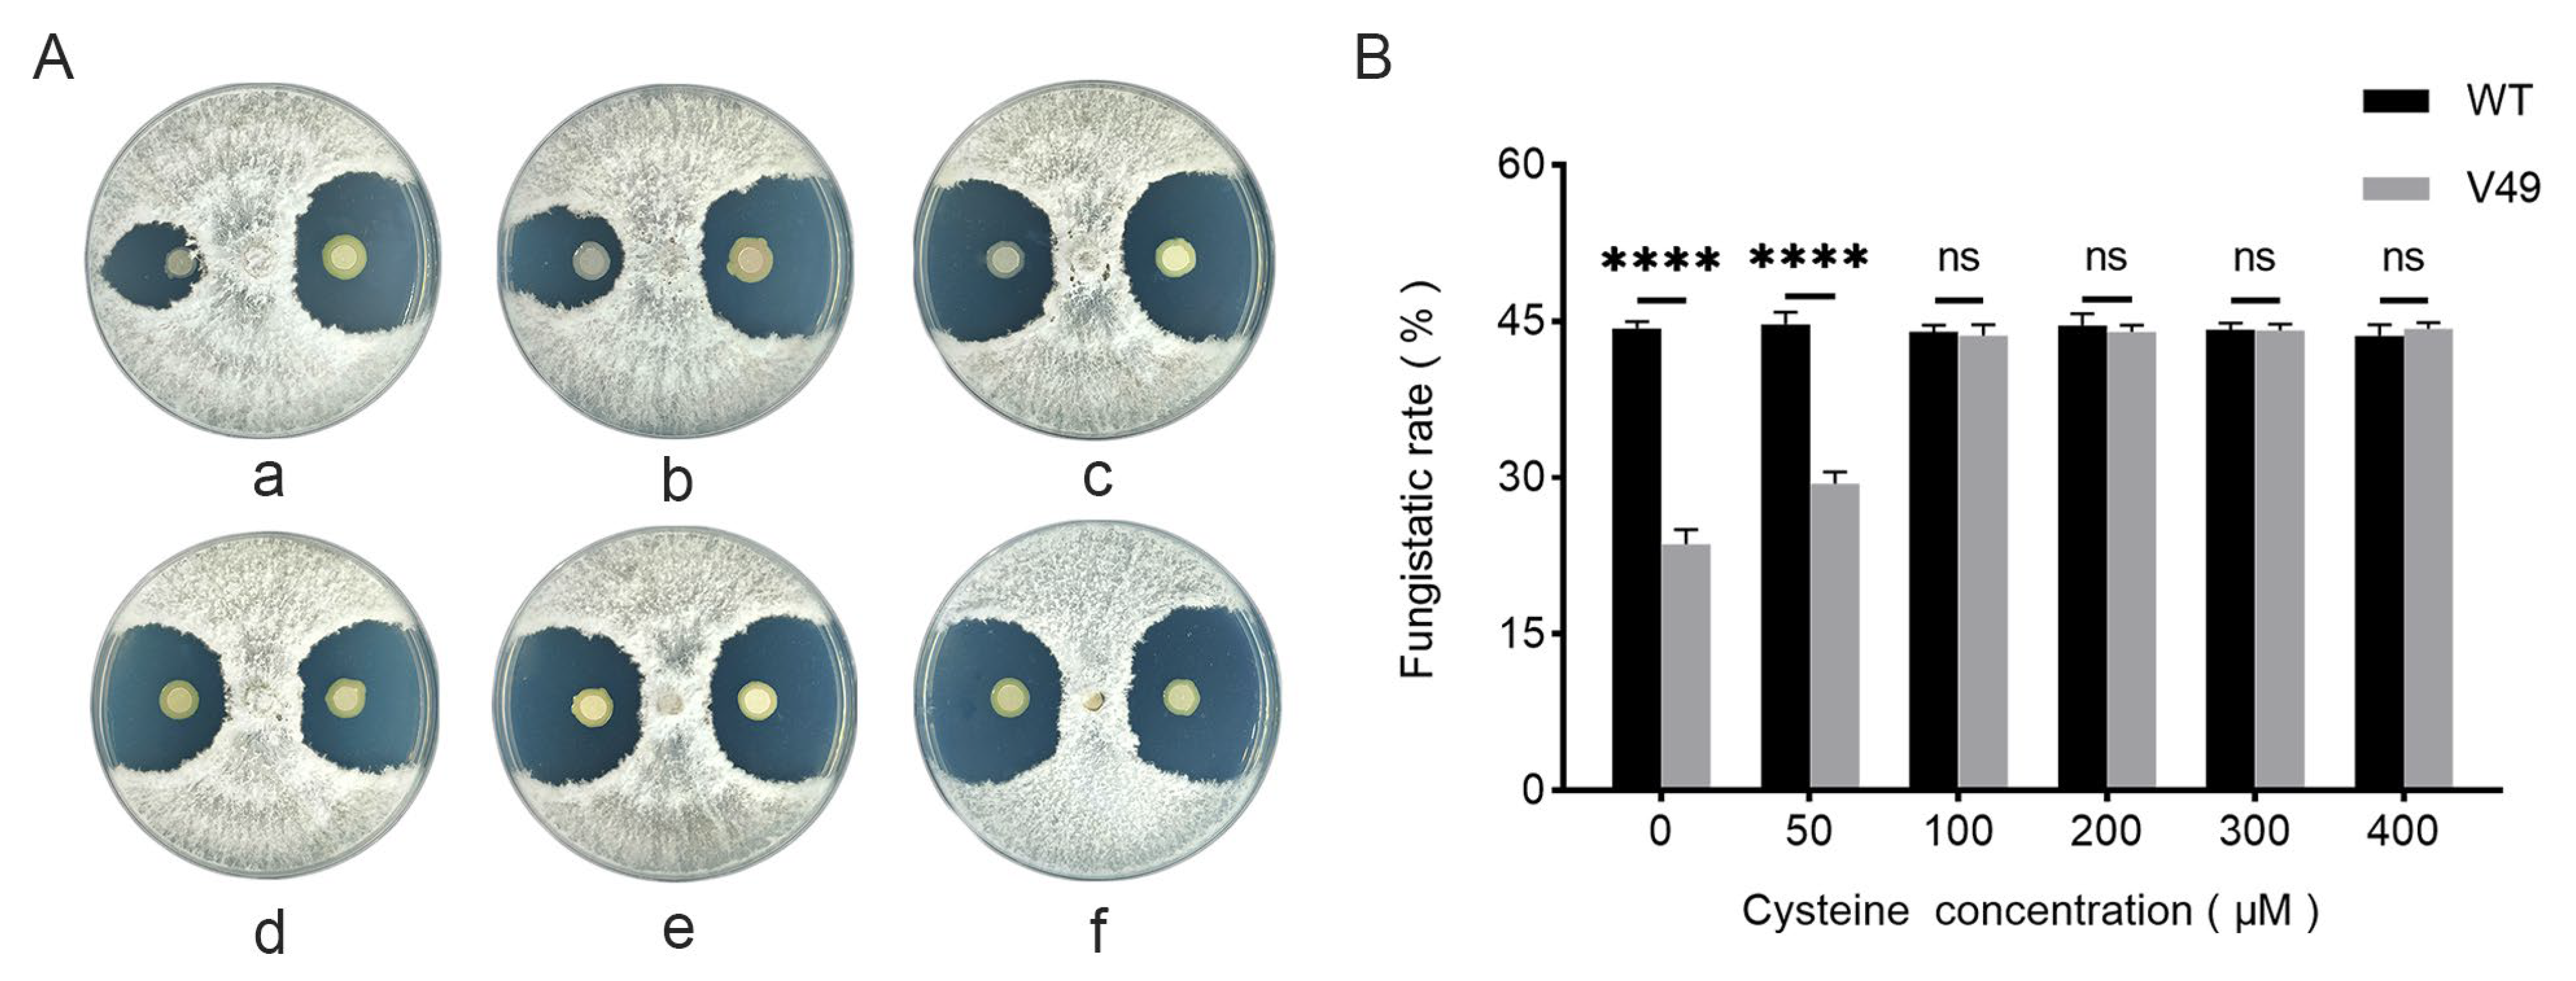
Ijms 24 08067 g004 Ijms 24 08067 g004

CysB Is a Key Regulator of the Antifungal Activity of Burkholderia pyrrocinia JK-SH007
Abstract
1. Introduction
2. Results
2.1. Differences in the Activities of WT and Mutant Strains of B. pyrrocinia JK-SH007 against Phomopsis Macrospora
2.2. Localization and Southern Blotting of Mutated Genes in the Mutant V49
2.3. Differences in Cysteine Content
2.4. Effect of Adding L-cysteine on the Antagonistic Ability of the Mutant V49
2.5. HPLC–MS Analysis to Identify Differentially Abundant Substances
2.6. The Addition of L-cysteine Restored the Siderophore Production Ability of the Mutant V49
2.7. The Transcriptome of B. pyrrocinia JK-SH007 Was Affected When CysB Was Disrupted
2.8. Predicted Targets of sRNAs
3. Discussion
4. Materials and Methods
4.1. Experimental Materials
4.2. Mutant Screening
4.3. Antagonism Test
4.4. Localization of Mutant Genes
4.5. Southern Blotting
4.6. Transcriptome Sequencing
4.7. Target Prediction for sRNAs
4.8. Real-Time Quantitative PCR
4.9. L-cysteine Measurement
4.10. CAS Assays to Detect Siderophore Production
4.11. L-cysteine Addition Experiment
4.12. HPLC–MS Analysis
4.13. Statistical Analysis
4.14. Data Availability
5. Conclusions
Supplementary Materials
Author Contributions
Funding
Institutional Review Board Statement
Informed Consent Statement
Data Availability Statement
Conflicts of Interest
References
- Kunakom, S.; Eustáquio, A.S. Burkholderia as a Source of Natural Products. J. Nat. Prod. 2019, 82, 2018–2037. [Google Scholar] [CrossRef] [PubMed]
- de Souza Carraro, D.; Carraro, R.M.; Campos, S.V.; Iuamoto, L.R.; de Oliveira Braga, K.A.; de Oliveira, L.C.; Sabino, E.C.; Rossi, F.; Pego-Fernandes, P.M. Burkholderia Cepacia, Cystic Fibrosis and Outcomes Following Lung Transplantation: Experiences from a Single Center in Brazil. Clinics 2018, 73, e166. [Google Scholar] [CrossRef]
- Goodlet, K.J.; Nailor, M.D.; Omar, A.; Huang, J.L.; LiPuma, J.J.; Walia, R.; Tokman, S. Successful Lung Re-Transplant in a Patient with Cepacia Syndrome Due to Burkholderia Ambifaria. J. Cyst. Fibros. 2019, 18, e1–e4. [Google Scholar] [CrossRef]
- Meza-Radilla, G.; Mendez-Canarios, A.; Xicohtencatl-Cortes, J.; Escobedo-Guerra, M.R.; Torres, A.G.; Antonio Ibarra, J.; Estrada-de los Santos, P. Misidentification of Burkholderia Pseudomallei and Other Burkholderia Species from Pediatric Infections in Mexico. Open Forum Infect. Dis. 2019, 6, ofz008. [Google Scholar] [CrossRef]
- Regan, K.H.; Bhatt, J. Eradication Therapy for Burkholderia Cepacia Complex in People with Cystic Fibrosis. Cochrane Database Syst. Rev. 2019, 2019, CD009876. [Google Scholar] [CrossRef] [PubMed]
- Lord, R.; Jones, A.M.; Horsley, A. Antibiotic Treatment for Burkholderia Cepacia Complex in People with Cystic Fibrosis Experiencing a Pulmonary Exacerbation. Cochrane Database Syst. Rev. 2020, 2020, CD009529. [Google Scholar] [CrossRef]
- Li, G.-X.; Wu, X.-Q.; Ye, J.-R. Biosafety and Colonization of Burkholderia Multivorans WS-FJ9 and Its Growth-Promoting Effects on Poplars. Appl. Microbiol. Biotechnol. 2013, 97, 10489–10498. [Google Scholar] [CrossRef]
- Xu, Z.; Wang, M.; Du, J.; Huang, T.; Liu, J.; Dong, T.; Chen, Y. Isolation of Burkholderia Sp. HQB-1, A Promising Biocontrol Bacteria to Protect Banana against Fusarium Wilt through Phenazine-1-Carboxylic Acid Secretion. Front. Microbiol. 2020, 11, 605152. [Google Scholar] [CrossRef]
- Patel, R.R.; Patel, D.D.; Bhatt, J.; Thakor, P.; Triplett, L.R.; Thakkar, V.R. Induction of Pre-Chorismate, Jasmonate and Salicylate Pathways by Burkholderia Sp. RR18 in Peanut Seedlings. J. Appl. Microbiol. 2021, 131, 1417–1430. [Google Scholar] [CrossRef]
- Heo, A.Y.; Koo, Y.M.; Choi, H.W. Biological Control Activity of Plant Growth Promoting Rhizobacteria Burkholderia Contaminans AY001 against Tomato Fusarium Wilt and Bacterial Speck Diseases. Biology 2022, 11, 619. [Google Scholar] [CrossRef] [PubMed]
- Esmaeel, Q.; Pupin, M.; Kieu, N.P.; Chataigne, G.; Bechet, M.; Deravel, J.; Krier, F.; Hofte, M.; Jacques, P.; Leclere, V. Burkholderia Genome Mining for Nonribosomal Peptidesynthetases Reveals a Great Potential for Novelsiderophores and Lipopeptides Synthesis. MicrobiologyOpen 2016, 5, 512–526. [Google Scholar] [CrossRef] [PubMed]
- Hammer, P.E.; Burd, W.; Hill, D.S.; Ligon, J.M.; Pée, K.-H. Conservation of the Pyrrolnitrin Biosynthetic Gene Cluster among Six Pyrrolnitrin-Producing Strains. FEMS Microbiol. Letters 1999, 180, 39–44. [Google Scholar] [CrossRef]
- Pawar, S.; Chaudhari, A.; Prabha, R.; Shukla, R.; Singh, D.P. Microbial Pyrrolnitrin: Natural Metabolite with Immense Practical Utility. Biomolecules 2019, 9, 443. [Google Scholar] [CrossRef] [PubMed]
- Jiao, Y.; Yoshihara, T.; Ishikuri, S.; Uchino, H.; Ichihara, A. Structural Identification of Cepaciamide A, a Novel Fungitoxic Compound from Pseudomonas Cepacia D-202. Tetrahedron Lett. 1996, 37, 1039–1042. [Google Scholar] [CrossRef]
- Hwang, J.; Chilton, W.S.; Benson, D.M. Pyrrolnitrin Production by Burkholderia Cepacia and Biocontrol of Rhizoctonia Stem Rot of Poinsettia. Biol. Control 2002, 25, 56–63. [Google Scholar] [CrossRef]
- Jung, B.K.; Hong, S.-J.; Park, G.-S.; Kim, M.-C.; Shin, J.-H. Isolation of Burkholderia Cepacia JBK9 with Plant Growth-Promoting Activity While Producing Pyrrolnitrin Antagonistic to Plant Fungal Diseases. Appl. Biol. Chem. 2018, 61, 173–180. [Google Scholar] [CrossRef]
- Yang, X.; Chen, X.; Song, Z.; Zhang, X.; Zhang, J.; Mei, S. Antifungal, Plant Growth-Promoting, and Mycotoxin Detoxication Activities of Burkholderia Sp. Strain XHY-12. 3 Biotech 2020, 10, 158. [Google Scholar] [CrossRef]
- Ji, Y.; Zhou, G.; Li, Z.; Wang, S.; Zhou, H.; Song, X. Triggers of Widespread Dieback and Mortality of Poplar (Populus Spp.) Plantations across Northern China. J. Arid. Environ. 2020, 174, 104076. [Google Scholar] [CrossRef]
- Ren, J.H.; Wu, X.Q.; Liu, H.; Ye, J.R. Isolation and Purification of Antifungal Protein from Burkholderia pyrrocinia JK-SH007. Microbiol. China 2010, 37, 872–880. [Google Scholar] [CrossRef]
- Netz, D.J.A.; Stuempfig, M.; Dore, C.; Muehlenhoff, U.; Pierik, A.J.; Lill, R. Tah18 Transfers Electrons to Dre2 in Cytosolic Iron-Sulfur Protein Biogenesis. Nat. Chem. Biol. 2010, 6, 758–765. [Google Scholar] [CrossRef]
- Fuss, J.O.; Tsai, C.-L.; Ishida, J.P.; Tainer, J.A. Emerging Critical Roles of Fe-S Clusters in DNA Replication and Repair. Biochim. Biophys. Acta-Mol. Cell Res. 2015, 1853, 1253–1271. [Google Scholar] [CrossRef] [PubMed]
- Laleve, A.; Vallieres, C.; Golinelli-Cohen, M.-P.; Bouton, C.; Song, Z.; Pawlik, G.; Tindall, S.M.; Avery, S.V.; Clain, J.; Meunier, B. The Antimalarial Drug Primaquine Targets Fe-S Cluster Proteins and Yeast Respiratory Growth. Redox Biol. 2016, 7, 21–29. [Google Scholar] [CrossRef]
- Liu, G.; Wang, Y.; Anderson, G.J.; Camaschella, C.; Chang, Y.; Nie, G. Functional Analysis of GLRX5 Mutants Reveals Distinct Functionalities of GLRX5 Protein. J. Cell. Biochem. 2016, 117, 207–217. [Google Scholar] [CrossRef] [PubMed]
- Sperandio, B.; Polard, P.; Ehrlich, D.S.; Renault, P.; Guedon, E. Sulfur Amino Acid Metabolism and Its Control in Lactococcus Lactis IL1403. J. Bacteriol. 2005, 187, 3762–3778. [Google Scholar] [CrossRef] [PubMed]
- Zimbler, D.L.; Park, T.M.; Arivett, B.A.; Penwell, W.F.; Greer, S.M.; Woodruff, T.M.; Tierney, D.L.; Actis, L.A. Stress Response and Virulence Functions of the Acinetobacter Baumannii NfuA Fe-S Scaffold Protein. J. Bacteriol. 2012, 194, 2884–2893. [Google Scholar] [CrossRef]
- Kozmin, S.G.; Stepchenkova, E.I.; Schaaper, R.M. TusA (YhhP) and IscS Are Required for Molybdenum Cofactor-Dependent Base-Analog Detoxification. MicrobiologyOpen 2013, 2, 743–755. [Google Scholar] [CrossRef]
- Nachin, L.; Loiseau, L.; Expert, D.; Barras, F. SufC: An Unorthodox Cytoplasmic ABC/ATPase Required for [Fe-S] Biogenesis under Oxidative Stress. Embo J. 2003, 22, 427–437. [Google Scholar] [CrossRef]
- Mashruwala, A.A.; Pang, Y.Y.; Rosario-Cruz, Z.; Chahal, H.K.; Benson, M.A.; Mike, L.A.; Skaar, E.P.; Torres, V.J.; Nauseef, W.M.; Boyd, J.M. Nfu Facilitates the Maturation of Iron-Sulfur Proteins and Participates in Virulence in Staphylococcus Aureus. Mol. Microbiol. 2015, 95, 383–409. [Google Scholar] [CrossRef]
- Jovanovic, M.; Lilic, M.; Savic, D.J.; Jovanovic, G. The LysR-Type Transcriptional Regulator CysB Controls the Repression of HslJ Transcription in Escherichia Coli. Microbiology 2003, 149, 3449–3459. [Google Scholar] [CrossRef]
- Kouzuma, A.; Endoh, T.; Omori, T.; Nojiri, H.; Yamane, H.; Habe, H. Transcription Factors CysB and SfnR Constitute the Hierarchical Regulatory System for the Sulfate Starvation Response in Pseudomonas Putida. J. Bacteriol. 2008, 190, 4521–4531. [Google Scholar] [CrossRef]
- Liu, H.; Hou, Y.; Wang, Y.; Li, Z. Enhancement of Sulfur Conversion Rate in the Production of L-Cysteine by Engineered Escherichia Coli. J. Agric. Food Chem. 2020, 68, 250–257. [Google Scholar] [CrossRef]
- Alvarez, R.; Neumann, G.; Fravega, J.; Diaz, F.; Tejias, C.; Collao, B.; Fuentes, J.A.; Paredes-Sabja, D.; Calderon, I.L.; Gil, F. CysB-Dependent Upregulation of the Salmonella Typhimurium CysJIH Operon in Response to Antimicrobial Compounds That Induce Oxidative Stress. Biochem. Biophys. Res. Commun. 2015, 458, 46–51. [Google Scholar] [CrossRef]
- Chen, M.; Zhang, W.; Han, L.; Ru, X.; Cao, Y.; Hikichi, Y.; Ohnishi, K.; Pan, G.; Zhang, Y. A CysB Regulator Positively Regulates Cysteine Synthesis, Expression of Type III Secretion System Genes, and Pathogenicity in Ralstonia Solanacearum. Mol. Plant Pathol. 2022, 23, 679–692. [Google Scholar] [CrossRef]
- Gomes, C.M.; Lemos, R.S.; Teixeira, M.; Kletzin, A.; Huber, H.; Stetter, K.O.; Schafer, G.; Anemuller, S. The Unusual Iron Sulfur Composition of the Acidianus Ambivalens Succinate Dehydrogenase Complex. Biochim Biophys Acta 1999, 1411, 134–141. [Google Scholar] [CrossRef]
- Marienhagen, J.; Kennerknecht, N.; Sahm, H.; Eggeling, L. Functional Analysis of All Aminotransferase Proteins Inferred from the Genome Sequence of Corynebacterium glutamicum. J. Bacteriol. 2005, 187, 7639–7646. [Google Scholar] [CrossRef]
- Fernandez, F.J.; de Vries, D.; Pena-Soler, E.; Coll, M.; Christen, P.; Gehring, H.; Cristina Vega, M. Structure and Mechanism of a Cysteine Sulfinate Desulfinase Engineered on the Aspartate Aminotransferase Scaffold. BBA-Proteins Proteom. 2012, 1824, 339–349. [Google Scholar] [CrossRef]
- Valer, L.; Rossetto, D.; Parkkila, T.; Sebastianelli, L.; Guella, G.; Hendricks, A.L.; Cowan, J.A.; Sang, L.; Mansy, S.S. Histidine Ligated Iron-Sulfur Peptides. Chembiochem 2022, 23, e202200202. [Google Scholar] [CrossRef] [PubMed]
- Fontenot, C.R.; Tasnim, H.; Valdes, K.A.; Popescu, C.V.; Ding, H. Ferric Uptake Regulator (Fur) Reversibly Binds a [2Fe-2S] Cluster to Sense Intracellular Iron Homeostasis in Escherichia Coli. J. Biol. Chem. 2020, 295, 15454–15463. [Google Scholar] [CrossRef] [PubMed]
- Fontenot, C.R.; Ding, H. Ferric Uptake Regulators (Fur) from Vibrio cholerae and Helicobacter pylori Bind a [2Fe-2S] Cluster in Response to Elevation of Intracellular Free Iron Content. Biometals 2022, 35, 591–600. [Google Scholar] [CrossRef] [PubMed]
- Johnson, D.C.; Dean, D.R.; Smith, A.D.; Johnson, M.K. Structure, Function, and Formation of Biological Iron-Sulfur Clusters. Annu. Rev. Biochem. 2005, 74, 247–281. [Google Scholar] [CrossRef]
- Bai, B.X.; Zhang, P.F.; Liu, R.X.; Ren, J.H.; Lei, H.Y. The Study on Resistance of Poplars Canker Disease Induced by Volatile Organic Compounds Released from Burkholderia pyrrocinia JK-SH007. Basic Clin. Pharmacol. Toxicol. 2018, 124, 11–12. [Google Scholar]
- Liu, W.-H.; Chen, F.-F.; Wang, C.-E.; Fu, H.-H.; Fang, X.-Q.; Ye, J.-R.; Shi, J.-Y. Indole-3-Acetic Acid in Burkholderia pyrrocinia JK-SH007: Enzymatic Identification of the Indole-3-Acetamide Synthesis Pathway. Front. Microbiol. 2019, 10, 2559. [Google Scholar] [CrossRef] [PubMed]
- Min, L.-J.; Wu, X.-Q.; Le, D.-W.; Chen, K.; Guo, L.; Ye, J.-R. Burkholderia Pyrrocinia JK-SH007 Enhanced Seed Germination, Cucumber Seedling Growth and Tomato Fruit via Catecholate-Siderophore-Mediation. Int. J. Agric. Biol. 2019, 22, 779–786. [Google Scholar] [CrossRef]
- Fu, H.; Chen, F.; Liu, W.; Kong, W.; Wang, C.; Fang, X.; Ye, J. Adding Nutrients to the Biocontrol Strain JK-SH007 Promotes Biofilm Formation and Improves Resistance to Stress. AMB Express 2020, 10, 32. [Google Scholar] [CrossRef]
- Poyraz, O.; Brunner, K.; Lohkamp, B.; Axelsson, H.; Hammarstrom, L.G.J.; Schnell, R.; Schneider, G. Crystal Structures of the Kinase Domain of the Sulfate-Activating Complex in Mycobacterium tuberculosis. PLoS ONE 2015, 10, e0121494. [Google Scholar] [CrossRef] [PubMed]
- Benoni, R.; De Bei, O.; Paredi, G.; Hayes, C.S.; Franko, N.; Mozzarelli, A.; Bettati, S.; Campanini, B. Modulation of Escherichia Coli Serine Acetyltransferase Catalytic Activity in the Cysteine Synthase Complex. FEBS Lett. 2017, 591, 1212–1224. [Google Scholar] [CrossRef]
- Nakatani, T.; Ohtsu, I.; Nonaka, G.; Wiriyathanawudhiwong, N.; Morigasaki, S.; Takagi, H. Enhancement of Thioredoxin/Glutaredoxin-Mediated L-Cysteine Synthesis from S-Sulfocysteine Increases L-Cysteine Production in Escherichia Coli. Microb. Cell. Fact. 2012, 11, 62. [Google Scholar] [CrossRef] [PubMed]
- Fujishiro, T.; Nakamura, R.; Kunichika, K.; Takahashi, Y. Structural Diversity of Cysteine Desulfurases Involved in Iron-Sulfur Cluster Biosynthesis. Biophys. Physicobiol. 2022, 19, e190001. [Google Scholar] [CrossRef]
- Deng, P.; Foxfire, A.; Xu, J.; Baird, S.M.; Jia, J.; Delgado, K.H.; Shin, R.; Smith, L.; Lu, S.-E. The Siderophore Product Ornibactin Is Required for the Bactericidal Activity of Burkholderia contaminans MS14. Appl. Environ. Microbiol. 2017, 83, e00051-17. [Google Scholar] [CrossRef] [PubMed]
- Lauhon, C.T.; Skovran, E.; Urbina, H.D.; Downs, D.M.; Vickery, L.E. Substitutions in an Active Site Loop of Escherichia Coli IscS Result in Specific Defects in Fe-S Cluster and Thionucleoside Biosynthesis in Vivo. J. Biol. Chem. 2004, 279, 19551–19558. [Google Scholar] [CrossRef]
- Fontecave, M.; Ollagnier-de-Choudens, S. Iron-Sulfur Cluster Biosynthesis in Bacteria: Mechanisms of Cluster Assembly and Transfer. Arch. Biochem. Biophys. 2008, 474, 226–237. [Google Scholar] [CrossRef]
- Xiao-Xue, C.; Liu-Fang, X.; Hua-Lin, S. Theoretical Studies on SRNA-Mediated Regulation in Bacteria. Chin. Phys. B 2015, 24, 128703. [Google Scholar] [CrossRef]
- Chareyre, S.; Mandin, P. Bacterial Iron Homeostasis Regulation by SRNAs. Microbiol. Spectr. 2018, 6, RWR-0010-2017. [Google Scholar] [CrossRef] [PubMed]
- Butt, A.T.; Banyard, C.D.; Haldipurkar, S.S.; Agnoli, K.; Mohsin, M.; Vitovski, S.; Paleja, A.; Tang, Y.; Lomax, R.; Ye, F.; et al. The Burkholderia Cenocepacia Iron Starvation Sigma Factor, OrbS, Possesses an on-Board Iron Sensor. Nucleic Acids Res. 2022, 50, 3709–3726. [Google Scholar] [CrossRef]
- Cooley, J.W.; Lee, D.-W.; Daldal, F. Across Membrane Communication between the Q(o) and Q(i) Active Sites of Cytochrome Bc(1). Biochemistry 2009, 48, 1888–1899. [Google Scholar] [CrossRef] [PubMed]
- Johnson, C.; England, A.; Munro-Ehrlich, M.; Colman, D.R.; DuBois, J.L.; Boyd, E.S. Pathways of Iron and Sulfur Acquisition, Cofactor Assembly, Destination, and Storage in Diverse Archaeal Methanogens and Alkanotrophs. J. Bacteriol. 2021, 203, e00117-21. [Google Scholar] [CrossRef] [PubMed]
- Sinha, P.K.; Nakamaru-Ogiso, E.; Torres-Bacete, J.; Sato, M.; Castro-Guerrero, N.; Ohnishi, T.; Matsuno-Yagi, A.; Yagi, T. Electron Transfer in Subunit NuoI (TYKY) of Escherichia Coli NADH:Quinone Oxidoreductase (NDH-1). J. Biol. Chem. 2012, 287, 17363–17373. [Google Scholar] [CrossRef]
- Yan, R.; Adinolfi, S.; Pastore, A. Ferredoxin, in Conjunction with NADPH and Ferredoxin-NADP Reductase, Transfers Electrons to the IscS/IscU Complex to Promote Iron-Sulfur Cluster Assembly. BBA-Proteins Proteom. 2015, 1854, 1113–1117. [Google Scholar] [CrossRef]
- Martins, B.M.; Svetlitchnaia, T.; Dobbek, H. 2-Oxoquinoline 8-Monooxygenase Oxygenase Component: Active Site Modulation by Rieske-[2Fe-2S] Center Oxidation/Reduction. Structure 2005, 13, 817–824. [Google Scholar] [CrossRef]
- Tian, T.; He, H.; Liu, X.-Q. The SufBCD Protein Complex Is the Scaffold for Iron-Sulfur Cluster Assembly in Thermus Thermophiles HB8. Biochem. Biophys. Res. Commun. 2014, 443, 376–381. [Google Scholar] [CrossRef]
- Talib, E.A.; Outten, C.E. Iron-Sulfur Cluster Biogenesis, Trafficking, and Signaling: Roles for CGFS Glutaredoxins and BolA Proteins. Biochim. Biophys. Acta-Mol. Cell Res. 2021, 1868, 118847. [Google Scholar] [CrossRef]
- Zheng, C.; Guo, S.; Tennant, W.G.; Pradhan, P.K.; Black, K.A.; Dos Santos, P.C. The Thioredoxin System Reduces Protein Persulfide Intermediates Formed during the Synthesis of Thio-Cofactors in Bacillus Subtilis. Biochemistry 2019, 58, 1892–1904. [Google Scholar] [CrossRef]
- Choby, J.E.; Mike, L.A.; Mashruwala, A.A.; Dutter, B.F.; Dunman, P.M.; Sulikowski, G.A.; Boyd, J.M.; Skaar, E.P. A Small-Molecule Inhibitor of Iron-Sulfur Cluster Assembly Uncovers a Link between Virulence Regulation and Metabolism in Staphylococcus aureus. Cell Chem. Biol. 2016, 23, 1351–1361. [Google Scholar] [CrossRef]
- Romsang, A.; Duang-nkern, J.; Saninjuk, K.; Vattanaviboon, P.; Mongkolsuk, S. Pseudomonas aeruginosa NfuA: Gene Regulation and Its Physiological Roles in Sustaining Growth under Stress and Anaerobic Conditions and Maintaining Bacterial Virulence. PLoS ONE 2018, 13, e0202151. [Google Scholar] [CrossRef]
- Blanchard, A.; Gora, C.; Golinelli-Cohen, M.-P. The Fe-S protein NfuA, a new key player in the virulence of Pseudomonas aeruginosa. Med. Sci. 2020, 36, 174–176. [Google Scholar] [CrossRef]
- Vergnes, A.; Viala, J.P.M.; Ouadah-Tsabet, R.; Pocachard, B.; Loiseau, L.; Meresse, S.; Barras, F.; Aussel, L. The Iron-Sulfur Cluster Sensor IscR Is a Negative Regulator of Spi1 Type III Secretion System in Salmonella enterica. Cell Microbiol. 2017, 19, e12680. [Google Scholar] [CrossRef]
- Balderas, D.; Mettert, E.; Lam, H.N.; Banerjee, R.; Gverzdys, T.; Alvarez, P.; Saarunya, G.; Tanner, N.; Zoubedi, A.; Wei, Y.; et al. Genome Scale Analysis Reveals IscR Directly and Indirectly Regulates Virulence Factor Genes in Pathogenic Yersinia. mBio 2021, 12, e00633-21. [Google Scholar] [CrossRef] [PubMed]
- Chen, F.; Ye, J.; Chio, C.; Liu, W.; Shi, J.; Qin, W. A Simplified Quick Microbial Genomic DNA Extraction via Freeze-Thawing Cycles. Mol. Biol. Rep. 2020, 47, 703–709. [Google Scholar] [CrossRef]
- Tjaden, B. De Novo Assembly of Bacterial Transcriptomes from RNA-Seq Data. Genome Biol. 2015, 16, 1. [Google Scholar] [CrossRef] [PubMed]
- Kery, M.B.; Feldman, M.; Livny, J.; Tjaden, B. TargetRNA2: Identifying Targets of Small Regulatory RNAs in Bacteria. Nucleic Acids Res. 2014, 42, W124–W129. [Google Scholar] [CrossRef] [PubMed]
- Rio, D.C.; Ares, M.J.; Hannon, G.J.; Nilsen, T.W. Purification of RNA Using TRIzol (TRI Reagent). Cold Spring Harb. Protoc. 2010, 2010, prot5439. [Google Scholar] [CrossRef] [PubMed]
- Rajeevan, M.S.; Ranamukhaarachchi, D.G.; Vernon, S.D.; Unger, E.R. Use of Real-Time Quantitative PCR to Validate the Results of CDNA Array and Differential Display PCR Technologies. Methods 2001, 25, 443–451. [Google Scholar] [CrossRef] [PubMed]
- Chatterjee, S.; Sonti, R.V. RpfF Mutants of Xanthomonas oryzae Pv. oryzae Are Deficient for Virulence and Growth under Low Iron Conditions. Mol. Plant-Microbe Interact. 2002, 15, 463–471. [Google Scholar] [CrossRef] [PubMed]
- Schwyn, B.; Neilands, J.B. Universal Chemical Assay for the Detection and Determination of Siderophores. Anal. Biochem. 1987, 160, 47–56. [Google Scholar] [CrossRef] [PubMed]

| Gene Name | Predicted Target Sites | Sequence (5′–3′) |
|---|---|---|
| Bp_007_sr1 | Iron–sulfur cluster assembly accessory protein | GCGCGGCATGAGCGCCGCGCGCGCCGCCGCGATCTGGGCCGCGCTGGCCGCCGTGGCCGCGTTGCTGTTCGTCGCATCGCTGTCGATCGGCAGCGTGCCGATGT |
| Bp_007_sr2 | Iron binding protein IscA for iron–sulfur cluster assembly | CTTGCCGTTCGGATCAAACAAAGAAGCGGCAAGGCGATCCCGAAGCCGCTTCATTTACCCTGGTACC |
| Bp_007_sr3 | Ferric uptake regulation protein FUR/Iron–sulfur binding oxidoreductase | AGGCGGCCCGCCGGGCACGCGGTTCGGGCCGGACGGCCGGTACCCCGGCGGTGCGGGCTGGGCCGAGGCGGC |
| Bp_007_sr4 | cysteine desulfurase | GGCTGCGCGGGCGAAGTTGGGCGGCGCGGCGCGCGGCGCACGCGTCGGGTGCGCAGGCGGGCCGGGCGCCAGCCGAGGCTGCCGATCATACCGGAGCACCGTGAATCCTGCCGGGCGCGGCGAACCGG |
| No. | Primer Name | Sequence (5′–3′) | Tm (°C) |
|---|---|---|---|
| 1 | Tn5-F | GCAAATTTATCCTGTGGCTG | 52.4 |
| 2 | Tn5-R | ACGAACCGAACAGGCTTATG | 55.3 |
| 3 | Tmp-F | AATTCACGAACCCAGTTGACA | 54.9 |
| 4 | Tmp-R | TAGGCCACACGTTCAAGTG | 54.9 |
| 5 | pyrG2-F | AGTCACCCTCCTCAAACTCG | 56.0 |
| 6 | pyrG2-R | TCGTGAAGTTGTTGGCCTTG | 56.0 |
| 7 | CysB-F | ATGAACCTGCACCAATTTCG | 54.0 |
| 8 | CysB-R | TTACAGTTCGTACGATTCGGATT | 54.6 |
| 9 | q-puuE-F | GGCGTGATGTGCGATTTCT | 56.1 |
| 10 | q-puuE-R | ACGATCTGGTAGGCGGTGT | 57.8 |
| 11 | q-gabD-F | GCACGAACCGCTTCTACG | 56.4 |
| 12 | q-gabD-R | AGCGCGTCCTCGATGTGT | 59.1 |
| 13 | q-vanA1-F | GTGCTCGTGTGCGGCTATCA | 60.2 |
| 14 | q-vanA1-R | CGGCTTCGGACGCATCGC | 62.0 |
| 15 | q-vanB-F | CGCCTGACGGCACGCACTT | 63.5 |
| 16 | q-vanB-R | CGCTTGTTCCTCCTCCGTCAGATA | 60.4 |
| 17 | q-vanA2-F | ACCTCGGCTATGTCCATCTGAA | 57.6 |
| 18 | q-vanA2-R | GGCGTGATGCCGTGGAAGC | 61.8 |
| 19 | q-CysD-F | GCTGTTGTTCTCGGGCGGCA | 63.0 |
| 20 | q-CysD-R | GCAGCGTCGTCTTGCGGTTC | 61.9 |
| 21 | q-CysE-F | CGGGCGGTTCCTGACGGGTA | 63.4 |
| 22 | q-CysE-R | GAACCGATCTTCGCACCCGC | 61.2 |
Disclaimer/Publisher’s Note: The statements, opinions and data contained in all publications are solely those of the individual author(s) and contributor(s) and not of MDPI and/or the editor(s). MDPI and/or the editor(s) disclaim responsibility for any injury to people or property resulting from any ideas, methods, instructions or products referred to in the content. |
© 2023 by the authors. Licensee MDPI, Basel, Switzerland. This article is an open access article distributed under the terms and conditions of the Creative Commons Attribution (CC BY) license (https://creativecommons.org/licenses/by/4.0/).
Share and Cite
Yu, M.; Tang, Y.; Lu, L.; Kong, W.; Ye, J. CysB Is a Key Regulator of the Antifungal Activity of Burkholderia pyrrocinia JK-SH007. Int. J. Mol. Sci. 2023, 24, 8067. https://doi.org/10.3390/ijms24098067
Yu M, Tang Y, Lu L, Kong W, Ye J. CysB Is a Key Regulator of the Antifungal Activity of Burkholderia pyrrocinia JK-SH007. International Journal of Molecular Sciences. 2023; 24(9):8067. https://doi.org/10.3390/ijms24098067
Chicago/Turabian StyleYu, Meng, Yuwei Tang, Lanxiang Lu, Weiliang Kong, and Jianren Ye. 2023. "CysB Is a Key Regulator of the Antifungal Activity of Burkholderia pyrrocinia JK-SH007" International Journal of Molecular Sciences 24, no. 9: 8067. https://doi.org/10.3390/ijms24098067
APA StyleYu, M., Tang, Y., Lu, L., Kong, W., & Ye, J. (2023). CysB Is a Key Regulator of the Antifungal Activity of Burkholderia pyrrocinia JK-SH007. International Journal of Molecular Sciences, 24(9), 8067. https://doi.org/10.3390/ijms24098067

